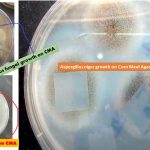
Corn Meal Agar (CMA) is a well established fungal medium which is a suitable substrate for chlamydospore production by Candida albicans and the maintenance of fungal stock cultures.This is a very simple formulation containing only cornmeal infusion and agar. The addition of glucose (0.2 g% w/v) to CMA will enhance the chromogenesis of some species of Trichophyton e.g. Trichophyton rubrum. Corn Meal Agar is an enrichment medium developed by Hazen and Reed for use in the cultivation of fungi. Walker and Huppert, in 1960, found that the addition of Tween 80 to Corn Meal Agar resulted in rapid and abundant chlamydospore formation.

Tag: Keynotes on CMA
CMA: Introduction, Principle, Composition, Test Procedure, Colony Characteristics and Uses
 Introduction of CMA CMA stands for Corn Meal Agar and...
Introduction of CMA CMA stands for Corn Meal Agar and...
Corn Meal Agar (CMA): Introduction, Principle, Composition, Test Procedure, Colony Characteristics and Uses
Introduction of Corn Meal Agar (CMA) Corn Meal Agar (CMA)...
Introduction of Corn Meal Agar (CMA) Corn Meal Agar (CMA)...
